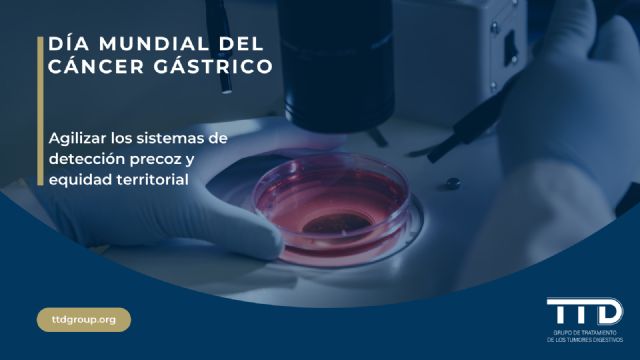
28 de noviembre, Día Mundial del Cáncer Gástrico - 1, Foto 1

Los especialistas en tumores digestivos apuntan que la incidencia moderada del cáncer gástrico dificulta la especialización de los centros de tratamiento de este tumor, y alegan la necesidad de crear una red dinámica con centros de referencia y centros colaboradores que garanticen la derivación ágil de los pacientes
Diversos estudios demuestran que los centros con un volumen de pacientes más amplio tienen más éxito en el tratamiento efectivo del cáncer gástrico, frente a los que presentan una incidencia más baja y por lo tanto una menor especialización
Los oncólogos también apuntan que este sistema acabaría con las diferencias territoriales entre comunidades autónomas e impulsaría la igualdad en el tratamiento para todos los ciudadanos
El cáncer gástrico es un "tumor silencioso" que presenta una supervivencia del 28% a cinco años, principalmente por la naturaleza variable del tumor y la ausencia de síntomas uniformes, lo que deriva en un diagnóstico tardío en la mayoría de las ocasiones
El Grupo TTD participará el próximo 27 de noviembre en la jornada 'Compromiso y acción con el cáncer gástrico desde el legislativo', que ha organizado la Asociación contra el Cáncer Gástrico y Gastrectomizados (ACCGG) y que tendrá lugar en el Senado de España
El cáncer gástrico sigue siendo un "tumor silencioso" en España. A pesar de que presenta una incidencia moderada de 7.500 casos al año, su mortalidad sigue siendo elevada, con un pronóstico de vida a cinco años del 28%. Entre los principales problemas a la hora de abordar el cáncer gástrico se encuentra el diagnóstico tardío, que viene dado por la ausencia de síntomas específicos y la falta de un sistema de detección precoz estructurado.
Por ello, los oncólogos del Grupo de Tratamiento de los Tumores Digestivos (TTD) han hecho una serie de recomendaciones para mejorar la detección y tratamiento de este tipo de tumores, con el objetivo de aumentar la esperanza y calidad de vida de los pacientes. Así, entre los principales consejos se encuentra la creación de una red nacional de centros de referencia y centros colaboradores, de manera que los pacientes puedan ser derivados de manera ágil a los hospitales donde el tratamiento puede aglutinar un grado más elevado de éxito.
En este sentido, diferentes estudios han demostrado que los centros con un mayor volumen de pacientes tienen acceso a terapias más punteras y procesos estandarizados, por lo que los resultados en el tratamiento son mucho más efectivos frente a los centros donde la especialización en un tumor específico es más baja.
Esto es especialmente relevante en el caso del cáncer gástrico, que presenta una incidencia baja en España y por lo tanto tiende a la dispersión territorial, circunstancia que dificulta la especialización de los equipos y de los centros. Por ello, los oncólogos del TTD consideran que la creación de un sistema nacional de centros de referencia, conectados a los centros colaboradores por un protocolo común de derivaciones dinámicas entre provincias y comunidades autónomas, podría ser la respuesta a la problemática de la detección tardía y aumentar la calidad de la atención asistencial.
"Una de las principales preocupaciones del TTD es garantizar el acceso equitativo de los pacientes a los últimos avances y terapias en el tratamiento del cáncer, especialmente en el caso del cáncer gástrico, que a pesar de que ocupa el noveno lugar en España por incidencia, presenta un alto nivel de mortalidad", ha indicado el doctor Fernando Rivera, presidente del Grupo TTD y jefe de servicio de Oncología Médica del Hospital Universitario Marqués de Valdecilla de Santander.
Dificultades en el diagnóstico y atención integrada
Uno de los principales motivos por los que el cáncer gástrico sigue presentando un bajo grado de supervivencia es el diagnóstico tardío, que se produce por la falta de síntomas específicos durante las fases iniciales y su evolución silenciosa. Por otro lado, se trata de un tumor con una gran heterogeneidad biológica, por lo que no se puede considerar una única enfermedad, sino un conjunto de subtipos tumorales con comportamientos y respuestas terapéuticas distintas.
A diferencia de otros tipos de cáncer, la aplicación de sistemas de cribado para la población general resultaría poco operativa, por lo que la detección depende de la sospecha clínica individual. Esta circunstancia ahonda en la necesidad de crear equipos especializados con capacidad para ofrecer una atención integrada.
En este sentido, la doctora Ana Fernández Montes, oncóloga médica en el Complejo Hospitalario Universitario de Ourense y secretaria del Grupo TTD, ha insistido en que centralizar los procedimientos complejos se asocia a mejores resultados clínicos y una menor mortalidad. "El cáncer gástrico requiere una atención multidisciplinar entre oncología médica, cirugía, oncología radioterápica, endocrinología, aparato digestivo, enfermería y psicología, entre otros muchos. Ya se ha demostrado que esta estructura multidisciplinar mejora el bienestar y la supervivencia de los pacientes, todo ello bajo la atención de un médico referente que gestione el recorrido del paciente".
Así, los oncólogos desaconsejan que todos los hospitales realicen cirugía gástrica rutinaria, debido a la baja incidencia y la alta complejidad de esta. En su lugar, recomiendan la creación de la red interhospitalaria con centros en los que se pueda ofrecer una atención clínica integral, con equipos multidisciplinares y especializados.
"Una atención integrada va más allá del tratamiento en sí mismo. También permite una mayor calidad de vida de los pacientes", ha señalado por su parte la doctora Tania Fleitas, oncóloga del Hospital Clínico de Valencia y miembro del comité traslacional del Grupo TTD. "La creación de unidades especializadas también aborda cuestiones como el desarrollo de servicios de apoyo nutricional, psicológico y social, así como integrar variables psicosociales al tratamiento clínico", ha concluido. Además, ha añadido la importancia de fomentar la investigación en resultados de salud por grupos de pacientes, para orientar las políticas y decisiones clínicas.
Investigación clínica e implantación de biomarcadores
Otra de las reivindicaciones de los oncólogos del TTD es integrar la investigación con la práctica clínica. Debido a la complejidad y diversidad de los tumores gástricos, el estudio de los biomarcadores es esencial para entender los subtipos, seleccionar los tratamientos y desarrollar estrategias de diagnóstico precoz.
"Los centros con una alta actividad investigadora presentan mejores resultados globales, incluso en los pacientes que no participan en los ensayos clínicos, gracias al conocimiento y preparación previa de los equipos", ha incidido la doctora Ana Fernández Montes.
En este sentido, los oncólogos del TTD insisten en la importancia de la investigación y la aplicación de nuevos avances y dianas terapéuticas al tratamiento de los tumores. Uno de los principales puntos de interés está en los biomarcadores, que permiten la clasificación molecular de los pacientes y el desarrollo de terapias dirigidas con un mayor grado de éxito.
Sin embargo, este tipo de terapias todavía tienen una implantación moderada en España. Mientras que algunas pruebas como HER2, PD-L1 y MSI sí que son de uso habitual, otros biomarcadores emergentes como CLDN18.2 todavía se encuentran muy limitados.
Es por ello que el TTD recomienda el desarrollo de la investigación en los centros y la implantación de las últimas técnicas y tecnologías en el tratamiento del cáncer gástrico.
Jornada divulgativa en el Senado
El Grupo TTD participará el próximo 27 de noviembre en una acción divulgativa en el Senado de España con la jornada 'Compromiso y acción con el cáncer gástrico desde el legislativo', que ha organizado la Asociación contra el Cáncer Gástrico y Gastrectomizados (ACCGG). En esta sesión participará el presidente del Grupo TTD, Fernando Rivera.
Esta jornada es una llamada a la implicación institucional y social para abordar el tratamiento del cáncer gástrico y garantizar la calidad de vida de los pacientes, desde el punto de vista asistencial e institucional. Así, a la sesión asistirán representantes de los cuatro principales partidos políticos, que participarán en una mesa de legisladores después de haber escuchado el testimonio de pacientes y profesionales médicos.
"Queremos concienciar sobre la importancia de mejorar el diagnóstico precoz, tratamiento del cáncer gástrico y calidad de vida del paciente, pero para ello es necesario contar con el apoyo institucional", ha indicado la presidenta de la asociación de pacientes ACCGG, Pilar Ruiz. En este sentido, ha señalado la importancia de acompañar las medidas de partidas presupuestarias, que permitan ampliar la investigación, conseguir los tratamientos más innovadores y aplicar terapias punteras. "También es esencial el acompañamiento a los pacientes y sus familiares desde el momento del diagnóstico, así como las campañas de prevención y concienciación", ha finalizado.
En cuanto a la situación del cáncer gástrico en España, el 65% de los casos se diagnostica en hombres, con una mayor presencia en personas mayores de 65 años. Entre los principales factores de riesgo se encuentran el consumo de elevado de sal -también de alimentos como salazones y ahumados-, el tabaquismo, la obesidad y el reflujo gástrico, así como la predisposición genética o la infección por Helicobacter pylori, que es la responsable del 87% de los casos de tumor gástrico no cardial.
Es por ello que entre las principales recomendaciones a nivel clínico para la prevención de este tipo de tumor se encuentra la erradicación del Helicobacter pylori, recomendado en familiares de primer grado de un paciente con cáncer gástrico como una de las medidas preventivas más eficaces, e identificar las familias de riesgo portadoras de mutaciones hereditarias.
Por su parte, en manos de la población se encuentra el fomento de un estilo de vida saludable, con una dieta rica en fruta y verduras y con consumo de sal moderado. Del mismo modo, también se recomienda la eliminación del tabaco y el alcohol y la crear hábitos de vida activos para evitar el sobrepeso, con la realización periódica de ejercicio físico.